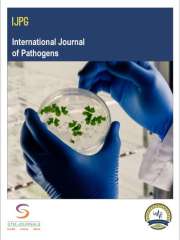
International Journal of Pathogens Journal Subscription

Research Methods Journal Subscription
Showing 1–24 of 31 results for Research Methods
-

Action Research
₹86,690 -

American Journal of Evaluation
₹112,928 -

Evaluation
₹104,684 -

Evaluation Review
₹207,773 -

International Journal of Animal Biotechnology and Applications
₹3,500 -

International Journal of I.C. Engines and Gas Turbines
₹3,500 -

International Journal of Internet Education
Original price was: ₹2,500.₹2,250Current price is: ₹2,250.20%
Off -
International Journal of Pathogens
₹3,500 -

International Journal of Political Science and Public Administration
Original price was: ₹3,500.₹3,150Current price is: ₹3,150.20%
Off -

International Review of Qualitative Research
₹59,743 -

Journal of Dravyaguna and Bhaishajya Vigyan
Original price was: ₹2,750.₹2,475Current price is: ₹2,475.20%
Off -

Journal of Interpretation Research
₹5,230 -

Journal of Kaumarbhritya and Stree Vigyan
Original price was: ₹2,750.₹2,475Current price is: ₹2,475.20%
Off -

Journal of Mixed Methods Research
₹107,166 -

Journal of Paediatrics and Child Health Nursing
Original price was: ₹2,750.₹2,475Current price is: ₹2,475.20%
Off -

Journal of Pharmacist and Hospital Pharmacy
Original price was: ₹2,800.₹2,520Current price is: ₹2,520.20%
Off -

Journal of Phytopharmacology and Phytomedicine
Original price was: ₹2,800.₹2,520Current price is: ₹2,520.20%
Off -

Journal of Radiation and Nuclear Applications
Original price was: ₹5,500.₹4,950Current price is: ₹4,950.20%
Off -

Journal of Shalya and Shalakya Vigyan
Original price was: ₹2,750.₹2,475Current price is: ₹2,475.20%
Off -

Journal of Swasthavritta and Yoga
Original price was: ₹2,750.₹2,475Current price is: ₹2,475.20%
Off -

Journal of Teachers and Teacher Education
Original price was: ₹2,750.₹2,475Current price is: ₹2,475.20%
Off














